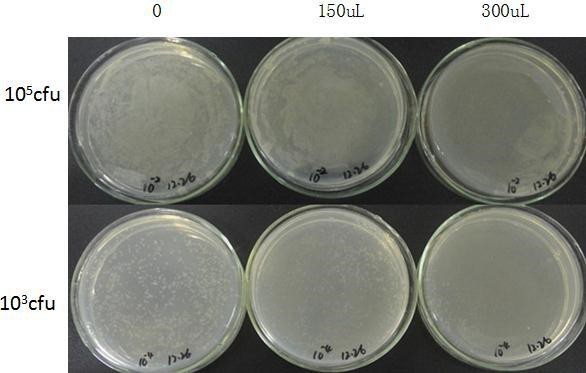
新闻图片3
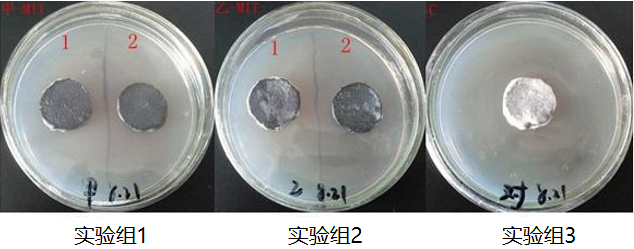
新闻图片5

爱必信(上海)生物科技有限公司品牌商
14 年
手机商铺
- NaN
- 0
- 0
- 2
- 2
推荐产品
公司新闻/正文
细胞培养之清洁大作战
701 人阅读发布时间:2022-09-06 08:54
2、培养基不浑浊,有丝状物质可以初步判断是真菌污染。
3、培养基不浑浊、没有丝状物质,但是细胞状态变差,生长变慢,在显微镜下观察可能会有小黑点,是细胞凋亡坏死,释放出大量碎片,看起来就像黑胶虫,细胞传代以后就出现细胞间黑点,细胞空泡化,很多类似凋亡、坏死的细胞,最终细胞漂浮,完全死亡。

| Absin为您提供安全、彻底、又高效的除菌全家桶,包含水浴锅抑菌剂(abs9371)、培养箱除菌剂(abs9372)、细胞房除菌剂(abs9373)、水盘抑菌剂(abs9374),由乳链菌肽、纳他霉素、尼泊金酯类、水等组成,无挥发性,分散均匀,热稳定性高。这套试剂能在湿度较大的条件下杀死常见的毛霉、黑霉、青霉、交链孢霉等霉菌孢子,并能抑制大多数的真菌和细菌生长,如大肠杆菌、枯草芽孢杆菌等。 |  |
喷洒试剂前 喷洒试剂前 |
喷洒试剂等待24h后 喷洒试剂等待24h后 |
| 清洁试剂 |
优劣势 |
| 酒精 |
有刺激性气味,只能用于擦拭物体表面,不可以用于水盘和水浴锅,且只能抑制微生物生长,不能杀灭,要杀灭需要长时间浸泡,已经污染真菌的实验室用酒精消毒效果不明显 |
| 甲醛 |
有刺激性气味有毒致癌 |
| 饱和硫酸铜 |
只能用于水盘且有腐蚀性 |
| 新洁尔灭 |
苯扎溴铵,对革兰阳性细菌作用较强,但对绿脓杆菌、抗酸杆菌和细菌芽孢无效 |
| 84消毒液 |
有一定的刺激性与腐蚀性,有挥发性。 |
| 发酵产品、无气味、无刺激性、无毒性、热稳定、无挥发性、安全环保。具有广谱和高效性,对真菌和细菌都有杀灭作用。 |
 |
 |
| 类型 |
支原体清除剂(abs9375) |
支原体预防剂(abs9376) |
| 有效成分 |
多肽 |
|
| 工作原理 |
1、支原体和细菌带负电荷,多肽带正电荷,互相吸引。 2、多肽作用于支原体细胞膜,使其穿孔,改变渗透压。 3、支原体对渗透压敏感,渗透压的突变可致细胞破裂死亡。 |
|
| 优势 |
1、相较于抗生素类,本品无耐药性 2、无二次污染,随着培养时间的延长,会被缓慢降解为氨基酸 3、细胞毒性小,已在多种细胞上进行过验证 |
|
| 区别 |
·100%清除支原体的污染; ·完全清除支原体,只需3-6天; ·清除血清、培养基中支原体污染;
|
·100%预防支原体的污染; ·广谱性,替代双抗; ·用于预防血清、培养基污染; ·用于发酵、细胞治疗等领域; |
| 使用范围 |
污染后清除支原体,部分敏感细胞,推荐1:2000处理6天 |
培养之前预防支原体污染 |
Absin特色产品线:
WB相关:ECL发光液、预染marker、预制胶;IHC相关:二抗试剂盒、组化笔;IP/CoIP试剂盒;激动剂/抑制剂;血清、BSA、蛋白酶K、CTB、TTX、CEE;凋亡试剂盒;呼吸爆发试剂盒;ELISA试剂盒;重组蛋白;抗体: 二抗、标签抗体、对照抗体;定制服务(抗体/多肽/蛋白/标记/检测)...
|
爱必信(上海)生物科技有限公司 联系邮箱:info@absin.cn 公众平台:爱必信生物 |









